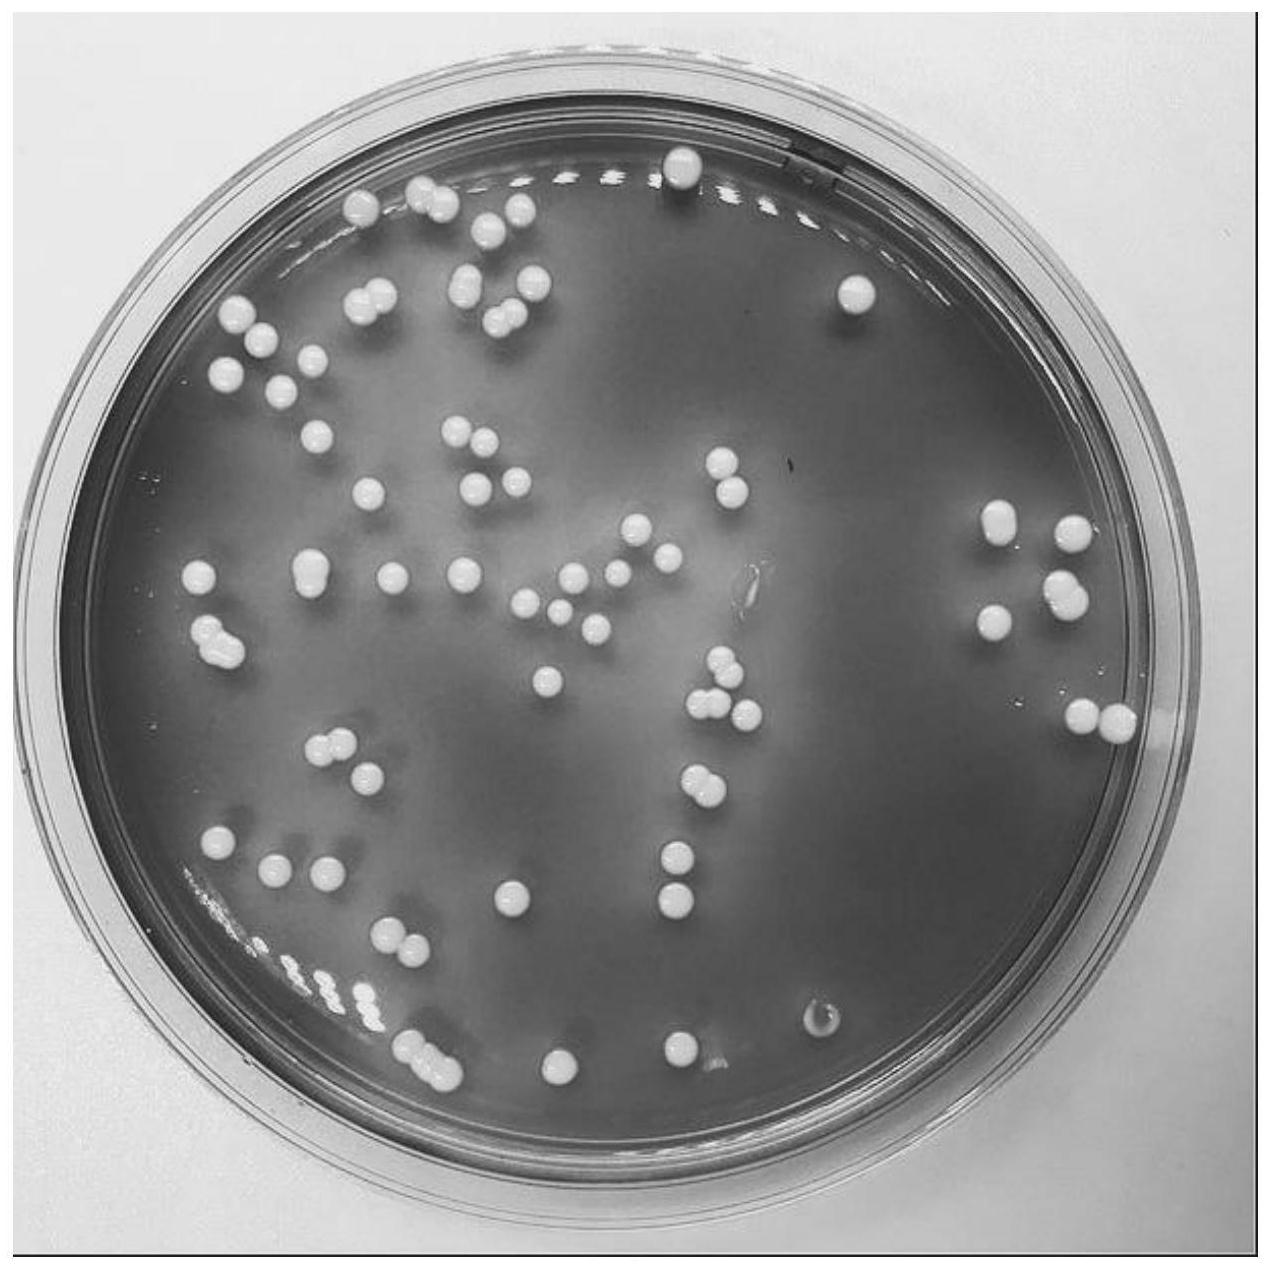
所述酿酒酵母保藏于中国微生物菌种保藏管理委员会普通微生物中心
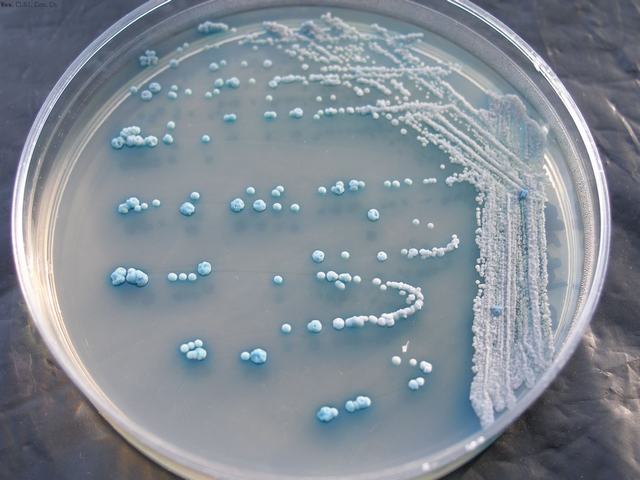
p>酿酒酵母( i>saccharomyces cerevisiae /i>),又称 a href="#"

酿酒酵母菌株

酵母菌
图片尺寸450x231
酿酒酵母菌的分类
图片尺寸319x330
白酒酿造环境和大曲之间酵母菌的结构特征分析一
图片尺寸740x547
p>酿酒酵母( i>saccharomyces cerevisiae /i>),又称 a href="#"
图片尺寸2288x1712
酿酒酵母y187菌种
图片尺寸1024x1365
酿酒酵母图片
图片尺寸450x300
新疆供应酿酒酵母菌,酿酒酵母
图片尺寸640x320
酿酒酵母图片
图片尺寸450x300
所述酿酒酵母保藏于中国微生物菌种保藏管理委员会普通微生物中心
图片尺寸1272x1272
酿酒酵母菌株的彩色扫描电子显微照片(图片来源:phys.org)
图片尺寸717x537
提高果酒色泽稳定性的酿酒酵母菌株fms4及用途的制作方法
图片尺寸1000x817
酵母菌酿酒酵母酵母照片
图片尺寸450x300
酿酒酵母图片
图片尺寸450x300
一株库德里阿兹威毕赤酵母菌及其在发酵白酒糟中的应用的制作方法
图片尺寸854x889
新分离高产乙醇的酿酒酵母菌株及其与产酯酵母共培养的培养方法与应用
图片尺寸414x438
p>酿酒酵母( i>saccharomyces cerevisiae /i>),又称 a href="#"
图片尺寸640x480
一种低温耐酸酿酒酵母菌及其筛选方法与应用与流程
图片尺寸732x744
一株库德里阿兹威毕赤酵母菌及其在发酵白酒糟中的应用
图片尺寸854x889
一株产酯香酿酒酵母菌及其应用的制作方法
图片尺寸443x428
酿酒酵母菌 200亿酵母菌 畜禽养殖饲料添加 酿酒酵母菌-阿里巴巴
图片尺寸800x800